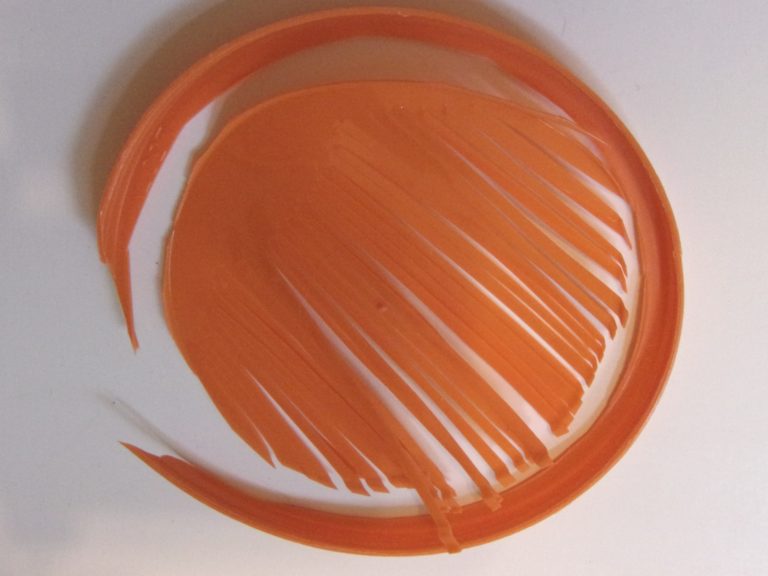

41 how do you remove labels from plastic containers
10 Ways to Prevent Food Spoilage Easily - Defiel Microorganisms Air Light Temperature Pests Humidity Time Signs of Food Spoilage Ways to Prevent Food Spoilage 1. Store It Right 2. Remove Your Spoiled Food 3. Separate Foods 4. Dry Your Food 5. Prevent Bacteria Growth by Depriving Them of Oxygen 6. Eat Leftovers 7. Don't Wash Fresh Produce Before Storing 8. Don't Freeze Already Contaminated Food 9. Ricoh's Laser Technology Poised to Contribute to a Circular Economy by ... Ricoh has developed an alternative to shrink labels on plastic bottles, drawing on core printing technologies to laser mark information on bottle surfaces. This ink- and label-free process slightly changes the bottles' surface, leaving necessary information in permanent white marks that are readable.
Uline: Privacy Policy Please contact Uline if you wish to opt out of partner marketing or update/ remove personal information. For information regarding interest-based ads, please visit Ads & Tracking . To opt out of catalog or direct mail, visit Marketing Preferences .

How do you remove labels from plastic containers
Can You Freeze Flour? Easy Guide To Freeze Flour | EatDelights Wrapping flour in plastic wrap is the best way to freeze it while still keeping it in its original packaging. Keep in mind that this method is certainly not the most economical one. The flour is difficult to scoop out once it has frozen and tends to stick together. Uline: Shopping Cart Uline stocks over 38,500 shipping boxes, packing materials, warehouse supplies, material handling and more. Same day shipping for cardboard boxes, plastic bags, janitorial, retail and shipping supplies. Plastic recycling - Wikipedia Plastic recycling is the reprocessing of plastic waste into new products. When performed correctly, this can reduce dependence on landfill, conserve resources and protect the environment from plastic pollution and greenhouse gas emissions. Although recycling rates are increasing, they lag behind those of other recoverable materials, such as aluminium, glass and paper.
How do you remove labels from plastic containers. How to Work Safely with - Static Electricity : OSH Answers When filling containers with low-conductivity liquids (i.e., ones with a conductivity less than 50 picoSiemens, pS), one should keep the grounded dip rod in the liquid for around 30 seconds after the filling is completed. Similarly, filling an ungrounded portable fuel tank on a plastic-lined truck bed can cause spark-induced gasoline fires. WHMIS 2015 - Labels : OSH Answers - Canadian Centre for Occupational ... Suppliers and employers must use and follow the WHMIS 2015 requirements for labels and safety data sheets (SDSs) for hazardous products sold, distributed, or imported into Canada. Please refer to the following other OSH Answers documents for more information: WHMIS 2015 - General. WHMIS 2015 - Pictograms. Splash Hog Urinal Screen S-23110 - Uline Uline stocks over 38,500 shipping boxes, packing materials, warehouse supplies, material handling and more. Same day shipping for cardboard boxes, plastic bags, janitorial, retail and shipping supplies. 10 Best Cat Food Storage Containers of 2022 - Excited Cats Check Price on Chewy. Check Price on Amazon. The Vittles Vault by Gamma2 is one of the most popular cat food containers today and with good reason. First off, it comes with the distinction of having the FDA's approval. Additionally, it is made from durable BPA-free plastic.
Mailing List Uline stocks over 38,500 shipping boxes, packing materials, warehouse supplies, material handling and more. Same day shipping for cardboard boxes, plastic bags, janitorial, retail and shipping supplies. ULINE Search Results: Cart Wheels Uline stocks over 38,500 shipping boxes, packing materials, warehouse supplies, material handling and more. Same day shipping for cardboard boxes, plastic bags, janitorial, retail and shipping supplies. 6 Best Cheap Large Planters For Outdoors of 2022 - Average Person Gardening Cover ¾ of your large and tall bucket with a well-mixed combination of loam garden soil, potting mix, peat moss, and sand. Step 4 Follow the specific planting spacing & depth requirements on each plant label to plant your desired plants. Step 5 Water your soil till it drains out of the box bottom. Water it daily or when the soil top gets dry. Can You Freeze Buttermilk? - CookThink Freeze for up to three months in the plastic containers. How to Thaw Buttermilk Refrigerate Overnight. The simplest way to thaw frozen buttermilk is to simply remove it from your freezer and place it directly into your fridge. Allow the frozen buttermilk to sit in your fridge overnight, and it will likely be thawed when you are ready to use it.
Specimen Packing and Transport - DynaLIFE We offer Transportation Services. For those not equipped to handle it, we can handle the logistics and remove the worry. DynaLIFE transportation representatives pick up and deliver laboratory specimens, laboratory reports, collection suppies and blood products. Our transportation schedule includes medical clinics, hospitals, extended care ... How Long Does Grapefruit Last? Does Grapefruit Go Bad? For commercially bottled grapefruit juice, the expiration date will be printed on the container. There's no hard and fast rule for how long fruit-based juices last, but typically they'll keep for one week when unopened or four days once it has been open. You can also freeze grapefruit juice for up to 3 months, but it's best to consume ... APL | Shipment Tracking Track my Shipment. Container, Bill of lading or Booking reference. To track up to three containers, please enter references separated by a comma as 'CMAU0000001, CMAU0000002, CMAU0000003'. Green Corner: Recycling - Eagle News Online Remove packing or film plastics in or around boxes. Containers: Must be empty and rinsed. Labels are okay. ... Plastic containers (Consumer Grade 1-7) ...

Free Printable Folger’s Coffee Can Labels | Coffee can crafts, Holiday coffee, Plastic coffee cans
The 9 Best TSA-Approved Containers of 2022 - TripSavvy Use the included pipette, funnel, and spatula to transfer products from your at-home containers to your new, travel-sized bottles. All of them feature non-toxic BPA-free plastic and are lightweight and break-resistant. You can wash and re-use them repeatedly and store them together in the included transparent zippered pouch.
Study Session 8 Solid Waste Reduction, Reuse and Recycling When you have studied this session, you should be able to: 8.1 Define and use correctly each of the terms printed in bold. (SAQs 8.1 and 8.2) 8.2 Use the waste hierarchy to identify the best ways of dealing with different wastes. (SAQ 8.2) 8.3 Give examples of how people and organisations can reduce waste.
Plastic recycling - Wikipedia Plastic recycling is the reprocessing of plastic waste into new products. When performed correctly, this can reduce dependence on landfill, conserve resources and protect the environment from plastic pollution and greenhouse gas emissions. Although recycling rates are increasing, they lag behind those of other recoverable materials, such as aluminium, glass and paper.
Uline: Shopping Cart Uline stocks over 38,500 shipping boxes, packing materials, warehouse supplies, material handling and more. Same day shipping for cardboard boxes, plastic bags, janitorial, retail and shipping supplies.
Can You Freeze Flour? Easy Guide To Freeze Flour | EatDelights Wrapping flour in plastic wrap is the best way to freeze it while still keeping it in its original packaging. Keep in mind that this method is certainly not the most economical one. The flour is difficult to scoop out once it has frozen and tends to stick together.

Post a Comment for "41 how do you remove labels from plastic containers"